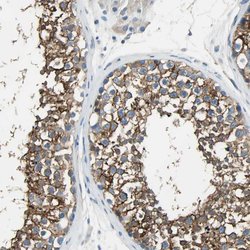
Invitrogen&trade;&nbsp;AKAP12 Polyclonal Antibody

missing translation for 'onlineSavingsMsg'
Learn More
Learn More
Invitrogen™ AKAP12 Polyclonal Antibody
Rabbit Polyclonal Antibody
Supplier: Invitrogen™ PA552281
Description
Immunogen sequence: QRAEAERPEE QAEASGLKKE TDVVLKVDAQ EAKTEPFTQG KVVGQTTPES FEKAPQVTES IESSELVTTC QAETLAGVKS QEMVMEQAIP PDSVETPTDS ETDGST Highest antigen sequence identity to the following orthologs: Mouse - 45%, Rat - 44%.
The A-kinase anchor proteins (AKAPs) are a group of structurally diverse proteins, which have the common function of binding to the regulatory subunit of protein kinase A (PKA) and confining the holoenzyme to discrete locations within the cell. This gene encodes a member of the AKAP family. The encoded protein is expressed in endothelial cells, cultured fibroblasts, and osteosarcoma cells. It associates with protein kinases A and C and phosphatase, and serves as a scaffold protein in signal transduction. This protein and RII PKA colocalize at the cell periphery. This protein is a cell growth-related protein. Antibodies to this protein can be produced by patients with myasthenia gravis. Alternative splicing of this gene results in two transcript variants encoding different isoforms.Specifications
| AKAP12 | |
| Polyclonal | |
| Unconjugated | |
| AKAP12 | |
| A kinase (PRKA) anchor protein (gravin) 12; A kinase (PRKA) anchor protein 12; AI317366; AKAP 250; AKAP12; AKAP-12; AKAP12A; AKAP12B; AKAP12G; AKAP250; A-kinase anchor protein 12; A-kinase anchor protein 250 kDa; A-kinase anchor protein, 250kDa; A-kinase anchoring protein 12; Gag12; gercelin; germ cell lineage protein gercelin; Gravin; kinase scaffold protein gravin; Myasthenia gravis autoantigen; myasthenia gravis autoantigen gravin; Srcs5; Src-Suppressed C Kinase Substrate; SSeCKS; SSeCKS, Gravin, AKAP250; testis specific gene A12; Tsga12; v-src suppressed transcript 5 | |
| Rabbit | |
| Antigen affinity chromatography | |
| RUO | |
| 9590 | |
| Store at 4°C short term. For long term storage, store at -20°C, avoiding freeze/thaw cycles. | |
| Liquid |
| Immunohistochemistry (Paraffin), Western Blot, Immunocytochemistry | |
| 0.1 mg/mL | |
| PBS with 40% glycerol and 0.02% sodium azide; pH 7.2 | |
| Q02952 | |
| AKAP12 | |
| Recombinant protein corresponding to Human AKAP12. Recombinant protein control fragment (Product #RP-102145). | |
| 100 μL | |
| Primary | |
| Human | |
| Antibody | |
| IgG |